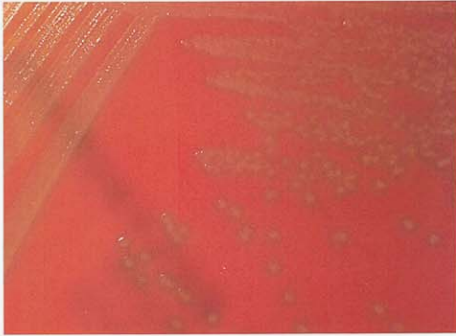
图 3 草绿色链球菌在血琼脂平板上的菌落特征(18~24h)
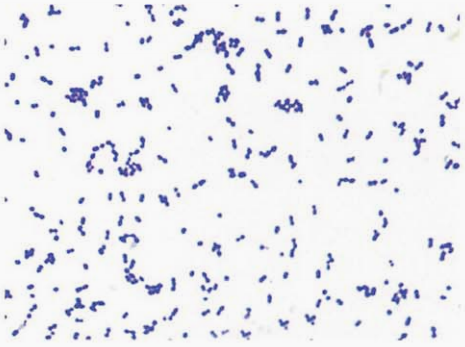
图 4 猪链球菌纯培养的镜下形态(革兰染色)
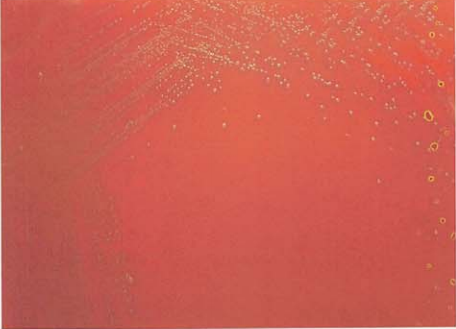
图 7 咽峡炎链球菌在血琼脂平板上的菌落特征(18~24h)

草绿色链球菌、猪链球菌及咽峡链球菌形态特征及生化反应
来源:武汉市灰藻生物科技有限公司 浏览量:93 发布时间:2025-12-29 12:54:57
一、草绿色链球菌 S. viridans
(一) 草绿色链球菌形态与染色
革兰阳性球菌,圆形或卵圆形,单个、成双或长链(细菌数>6个)排列(图 1)。在血培养阳性肉汤涂片中,长链状排列更加明显(图 2)。
(二) 草绿色链球菌培养特性
在5% CO₂环境下血平板上菌落生长良好。在血琼脂平板上35℃培养18~24h,形成针尖大小、灰色、凸起、边缘不齐、干燥、有α溶血环的菌落(图 3)。

图 1 草绿色链球菌纯培养的镜下形态(革兰染色)

图 2 草绿色链球菌血培养阳性肉汤涂片的镜下形态(革兰染色)
图 3 草绿色链球菌在血琼脂平板上的菌落特征(18~24h)
(三) 草绿色链球菌生化反应
触酶试验阴性,主要生化反应见表 1。
表 1 草绿色链球菌的主要生化反应
| 试验 | 结果 | 试验 | 结果 |
| 杆菌肽 | V | PYR | — |
| SXT | S | 胆汁七叶苷 | V |
| 胆汁溶菌 | — | 6.5% NaCl生长 | — |
| 马尿酸钠 | V | Optochin | R |
注:—,90%以上菌株阴性;S,敏感;R,耐药;V,反应不定。SXT,复方磺胺甲噁唑
(四) 草绿色链球菌鉴别要点
- 本菌特征:革兰阳性球菌,单个、成双或长链状排列,菌落针尖大小、有α溶血环,触酶试验阴性,Optochin试验耐药。
- 与非肠球菌、肺炎链球菌的鉴别 见表 2。
表 2草绿色链球菌与非肠球菌、肺炎链球菌鉴别的关键试验
| 菌名 | 溶血 | 杆菌肽 | 马尿酸盐 | 胆汁七叶苷 | Optochin | 胆汁溶菌 |
| 草绿色链球菌 | α, N | V | V | V | R | — |
| 非肠球菌 | α, N | R | — | + | R | — |
| 肺炎链球菌 | α | V | — | — | S | + |
注:N,不溶血;+,90%以上菌株阳性;—,90%以上菌株阴性;V,11%~89%菌株阳性;S,敏感;R,耐药
(五) 草绿色链球菌药敏试验的药物种类选择
草绿色链球菌抗菌药物选择见表 3。
表 3药敏试验的药物种类选择
| 抗菌药物名称 | |
| 必选 | 青霉素、氨苄西林 |
| 可选 | 头孢呋肟、头孢噻肟、头孢曲松、万古霉素 |
| 补选 | 奥利万星、特拉万星、红霉素、氯霉素、克林霉素、利奈唑胺、特地唑胺 |
注:具体参照CLSI M100-S26版及最新版本
(六) 草绿色链球菌结果解释与要点提示
草绿色链球菌又称为甲型(α)溶血性链球菌,是人体的正常菌群之一,分布于上呼吸道、胃肠道和女性生殖道,以口腔分布为最多。通常是不致病的,对于分离自正常无菌部位(如脑脊液、血液、骨髓)的草绿色链球菌,应使用MIC法检测青霉素的敏感性。
链球菌草绿色群包括:变异群(mutans group)、唾液群(salivarius group)、牛群(bovis group)、咽峡群(anginosus group)(以前称为“米勒链球菌”群)以及缓症群(mitis group),共5个群,每个群有几个种类。咽峡群包括含A、C、F和G群抗原的β溶血小菌落。
草绿色链球菌可引起菌血症,并在有损伤的心脏瓣膜处定居繁殖,引起急性细菌性心内膜炎。
二、猪链球菌 S. suis
(一) 猪链球菌形态与染色
革兰阳性球菌,呈卵圆形,单个或成双、短链排列(图 4)。
图 4 猪链球菌纯培养的镜下形态(革兰染色)
(二) 猪链球菌培养特性
在羊血琼脂平板上35℃培养18~24 h出现细小、圆形、凸起、α溶血的灰白色菌落(图 5)。部分菌株在马血琼脂平板上呈β溶血。

图 5 猪链球菌在血琼脂平板上的菌落特征(18~24h)
(三) 猪链球菌生化反应
触酶试验阴性,主要生化反应见表 4。
表 4 猪链球菌主要生化反应
| 试验 | 结果 | 试验 | 结果 |
| 葡萄糖 | + | 七叶苷 | + |
| 乳糖 | + | 精氨酸双水解酶 | + |
| 海藻糖 | + | 淀粉水解 | + |
| 棉子糖 | + | VP | — |
| 甘露醇 | — | 马尿酸钠 | — |
| 山梨醇 | — | 45℃生长 | — |
| 阿拉伯糖 | — | 6.5% NaCl生长 | — |
| 核糖 | — | pH9.6肉汤生长 | — |
注:+,90%以上菌株阳性;—,90%以上菌株阴性
(四) 猪链球菌鉴别要点
- 本菌特征:革兰阳性球菌,卵圆形,血琼脂平板上α溶血,菌落细小,分解葡萄糖等多种糖,七叶苷试验阳性,马尿酸钠试验阴性。
- 与其他链球菌的鉴别:猪链球菌具有链球菌属的生化特性,可根据血清学试验加以鉴别。
(五) 猪链球菌药敏试验的药物种类选择
猪链球菌抗菌药物选择见表 5。
表 5 药敏试验的药物种类选择
| 抗菌药物名称 | |
| 必选 | 青霉素、氨苄西林 |
| 可选 | 头孢呋肟、头孢噻肟、头孢曲松、万古霉素 |
| 天然耐药 | 夫西地酸、氨基糖苷类、安曲南、多黏菌素B |
注:具体参照CLSI M100-S26版及最新版本
(六) 猪链球菌结果解释与要点提示
- 猪链球菌能引起人畜共患的急性传染病,主要通过伤口感染。可引起猪的急性脓毒症、脑膜炎、关节炎、心内膜炎、肺炎等疾病。部分菌株可引起人类感染,造成细菌性脑炎或中毒样休克综合征。
- 猪链球菌的治疗应根据药敏试验结果,选择对其敏感的抗菌药物。对菌血症型及脑膜脑炎型,应早期大剂量使用抗菌药物或磺胺类药物。
- 根据菌体荚膜抗原特性的不同,可以分成35个血清型及相当数量难以定型的菌株,引起人和猪发病的猪链球菌以Lancefield血清群R群血清Ⅱ型为主。
- 该菌引起的猪链球菌病是国家规定的二类动物疫源性疾病,可通过呼吸道传播,实验室人员易发生交叉感染,因此在处理疑似猪链球菌的标本过程中均应在二级以上的生物安全柜内进行。
- 猪链球菌药物治疗选择见表 6。
表 6 猪链球菌药物治疗选择
| 首选 | 次选 | 其他有效药物 |
| 青霉素 | 万古霉素或头孢曲松、青霉素除外所有的β-内酰胺类药物均可选用 | 避免氟喹诺酮类、大环内酯类耐药上升,呋喃酮类药物也有效 |
注:具体参照《热病:桑福德抗微生物治疗指南》(新译第44版)
*《国家抗微生物治疗指南》推荐*
三、咽峡炎链球菌 S. anginosus
(一) 咽峡炎链球菌形态与染色
革兰阳性球菌,成双或短链排列(图 6)。

图 6咽峡炎链球菌纯培养的镜下形态(革兰染色)
(二) 咽峡炎链球菌培养特性
在5% CO₂环境下生长良好。在血琼脂平板上35℃培养18~24 h,形成细小、针尖大,有α、β溶血环,灰白色的菌落(图 7)。
图 7 咽峡炎链球菌在血琼脂平板上的菌落特征(18~24h)
(三) 咽峡炎链球菌生化反应
触酶试验阴性,杆菌肽试验阳性。主要生化反应见表 7。
表 7 咽峡炎链球菌主要生化反应
| 试验 | 结果 | 试验 | 结果 |
| 岩藻糖苷酶 | — | β-D-葡萄糖苷酶 | + |
| N-乙酰葡萄糖苷酶 | — | β-D-半乳糖苷酶 | V |
| β-N-乙酰氨基半乳糖苷酶 | — | 甘露醇 | V |
| 神经氨酸酶 | — | 山梨醇 | — |
| α-D-葡萄糖苷酶 | V | 精氨酸双水解酶 | + |
| 乳糖 | + | 七叶苷 | + |
| VP | + | 脲酶 | — |
注:+,90%以上菌株阳性;—,90%以上菌株阴性;V,11%~89%菌株阳性
(四) 咽峡炎链球菌鉴别要点
- 本菌特征:革兰阳性球菌,成双或短链排列,菌落较小,触酶试验、CAMP试验均阴性。七叶苷试验阳性。
- 与星座链球菌的鉴别:咽峡炎链球菌 β-D-葡萄糖苷酶试验阳性,而星座链球菌则为阴性。
(五) 咽峡炎链球菌药敏试验的药物种类选择
参见星座链球菌章节。
(六) 咽峡炎链球菌结果解释与要点提示
咽峡炎链球菌属米勒链球菌群,该菌引起心内膜炎在国内报道比较罕见。因此临床及检验人员对少见菌的检出应引起足够重视。
参考文献
周庭银, 章强强 主编. 临床微生物学诊断与图解(第4版)[M]. 上海: 上海科学技术出版社, 2019.
相关产品
HZB355184:猪链球菌 | Streptococcus suis
HZB912924:咽峡炎链球菌 | Streptococcus anginosus
敬请关注灰藻生物,共筑健康未来!
— 武汉市灰藻生物科技有限公司团队敬上
灰藻生物:我们期待着与客户共同成长,共创生命科学的美好未来!
更新日期:2025-12-25
编制人:木木
审稿人:小藻